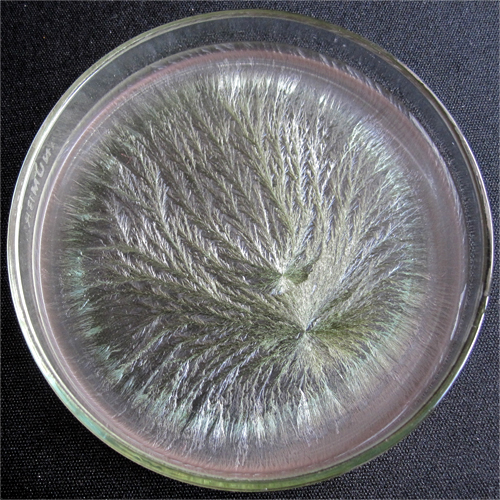
slideshow

IVAN ARROYO
Arquitectura Artes_Visuales Artes_Plásticas
INICIO
Cristalización sensible / Sensitive Crystallization
Instalación interactiva. (en proceso)
Interactive installation. (in progress)
Todos los seres vivos llevan dentro de sí la potencialidad de reproducir la esencia de su propia forma. Es posible, mediante el método de cristalización sensible codificar y descodificar esta potencialidad.
All living things share the characteristic of carrying within themselves the potential to reproduce the essence of their own form. It is possible, through the sensitive crystallization method encode and decode this potential.
Pfeiffer descubrió que un proceso de cristalización mineral, el de cualquier sal al deshidratarse, produce la formación de estructuras cristalinas geométricas, que se ven alteradas cuando en la probeta se mezcla la sal con una sustancia orgánica cualquiera, dando lugar a patrones morfológicos identificables. Teniendo en cuenta este fenómeno, el científico alemán diseñó un método para optimizar y sistematizar el proceso de cristalización y así poder comparar y analizar los resultados.
El método plasma en una placa de Petri la capacidad vital del organismo, codificada en la forma de un cristal de cloruro de cobre. Adjuntas, se encuentran un par de imágenes del resultado de algunas pruebas preliminares.
Pfeiffer discovered that a mineral crystallization process, wich produces the geometrical formation of crystalline structures, is altered when, in the probe, the salt is mixed with any organic substance, resulting the crystallization in new morphological patterns.
The method encodes, on a Petri dish, the vital capacity of an organic probe, in the form of a crystal of copper chloride. Attached, you will find a couple of pictures of the results of preliminary testing.
Una de las primeras pruebas de este trabajo de aproximación artística, a las investigaciones del científico alemán Ehrenfried Pfeiffer, sobre el método de cristalización sensible de su invención.
One of the first tests of this artistic approach to the research of the german scientist Ehrenfried Pfeiffer, on the sensitive crystalization method of his invetion.
Fecha / date: marzo 2013.